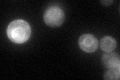
YML105C
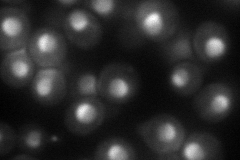
YML105C
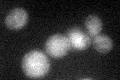
YML105C

View description
Subunit of the signal recognition particle (SRP), involved in protein targeting to the ER; interacts with Srp54p; homolog of mammalian SRP19
Localization:
Intensity:
Fold change:
Significance:
-
C’ GFP library in SD
ER36.58 -
N' NOP1pr-GFP in SD

nucleolus192.261 -
N' TEF2pr-mCherry in SD
nucleus,nucleolus88.7088 -
N' NATIVEpr-GFP in SD

ER66.2746 -
N' TEF2pr-VC and Cyto-VN in SD

#N/A0 -
C’ GFP library in SD+DTT

ER25.270.69Yes -
C’ GFP library in SD+H2O2

ER27.140.74No -
C’ GFP library in Starvation Media
ER37.181.01No -
C’ GFP library on the background of Pup2-DaMP

ER -
C’ GFP library on the background of CCT mutant

ER61.01341.66784Yes
